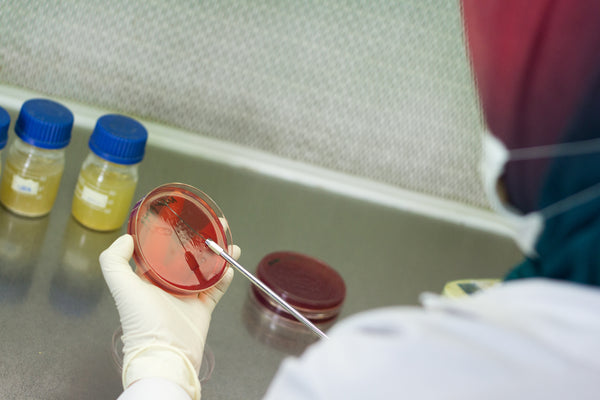

Xbido – Energy & Vitality
Thomson XBIDO: Master Your Vitality & Peak Performance
More Energy. Greater Stamina. Zero Limits.
Are you feeling tired by midday? Has your performance in sports or daily life started to decline? Thomson XBIDO is a scientifically-backed vitality booster designed to recharge your body’s natural energy reserves. Formulated with patented extracts and Japanese activated technology, XBIDO doesn’t just give you a temporary buzz—it strengthens your stamina, clears mental fog, and supports healthy blood circulation for peak physical and cognitive performance.

## Why XBIDO is the Gold Standard in Vitality
Unlike generic supplements, XBIDO uses high-purity, patented ingredients that show visible results in as little as 3 to 5 days:
-
Patented PHYSTA® Tongkat Ali: A clinically-researched water extract that naturally increases muscle strength, energy levels, and healthy libido.
-
Red Panax Ginseng: Known as the “King of Herbs,” it boosts your immune system and provides long-lasting stamina for demanding days.
-
Activated Ginkgo Biloba: Using Japanese technology to improve blood flow throughout the body, ensuring your brain and muscles get the oxygen they need.
-
Patented VENETRON®: A unique Rafuma leaf extract that calms the mind, helping you stay focused and stress-free while staying active.

## Real Stories from Our Community
⭐⭐⭐⭐⭐ 5.0/5 | Based on Real Life Results
“From 4 Games to 8 Games of Badminton!” “I used to struggle with 6 games of badminton, but after taking XBIDO, I can play 8 games with ease. My stamina has reached a completely different level.” — B Lim
“No More Afternoon Naps” “At 63, I used to need a nap every single afternoon. Since starting Thomson XBIDO, I feel energized all day long. It has truly changed my daily routine.” — Shum YC
## Quality You Can Trust
We don’t outsource quality. Every bottle of XBIDO is manufactured in-house in Singapore under strict GMP-compliant standards.
-
Scientifically Validated: Periodically tested for active ingredient integrity (HPLC) and dissolution.
-
Hormone-Free: 100% natural botanical ingredients with no added hormones.
-
Purity Guaranteed: Internally and externally tested by accredited 3rd party laboratories.

## Frequently Asked Questions (FAQ)
Q: How soon will I feel the effects? A: Most users report a noticeable boost in energy, alertness, and physical performance within 3 to 5 days of consistent use.
Q: Can women take Thomson XBIDO? A: Yes! XBIDO is excellent for women looking to improve their daily stamina and athletic performance. (Note: Not recommended for pregnant or breastfeeding women).
Q: Does it have any side effects? A: Due to the Ginkgo Biloba content, some users may experience temporary mild stomach upset or headaches. This is normal as your body adjusts to improved blood circulation.
## 🔥 LIMITED BATCH SPECIAL
Save up to 70% Today! Don’t miss out on our limited-time offer to reclaim your vitality at the best price ever.
[ADD TO CART — POWER UP YOUR LIFE]
## 🎁 Share Your Story & Get Rewarded
-
20% Voucher: Leave a review and receive an instant discount for your next order.
-
Win a Free Product: Share a “Show & Tell” video of your XBIDO journey, and you could be selected to receive a free Thomson product!
Reviews
There are no reviews yet.